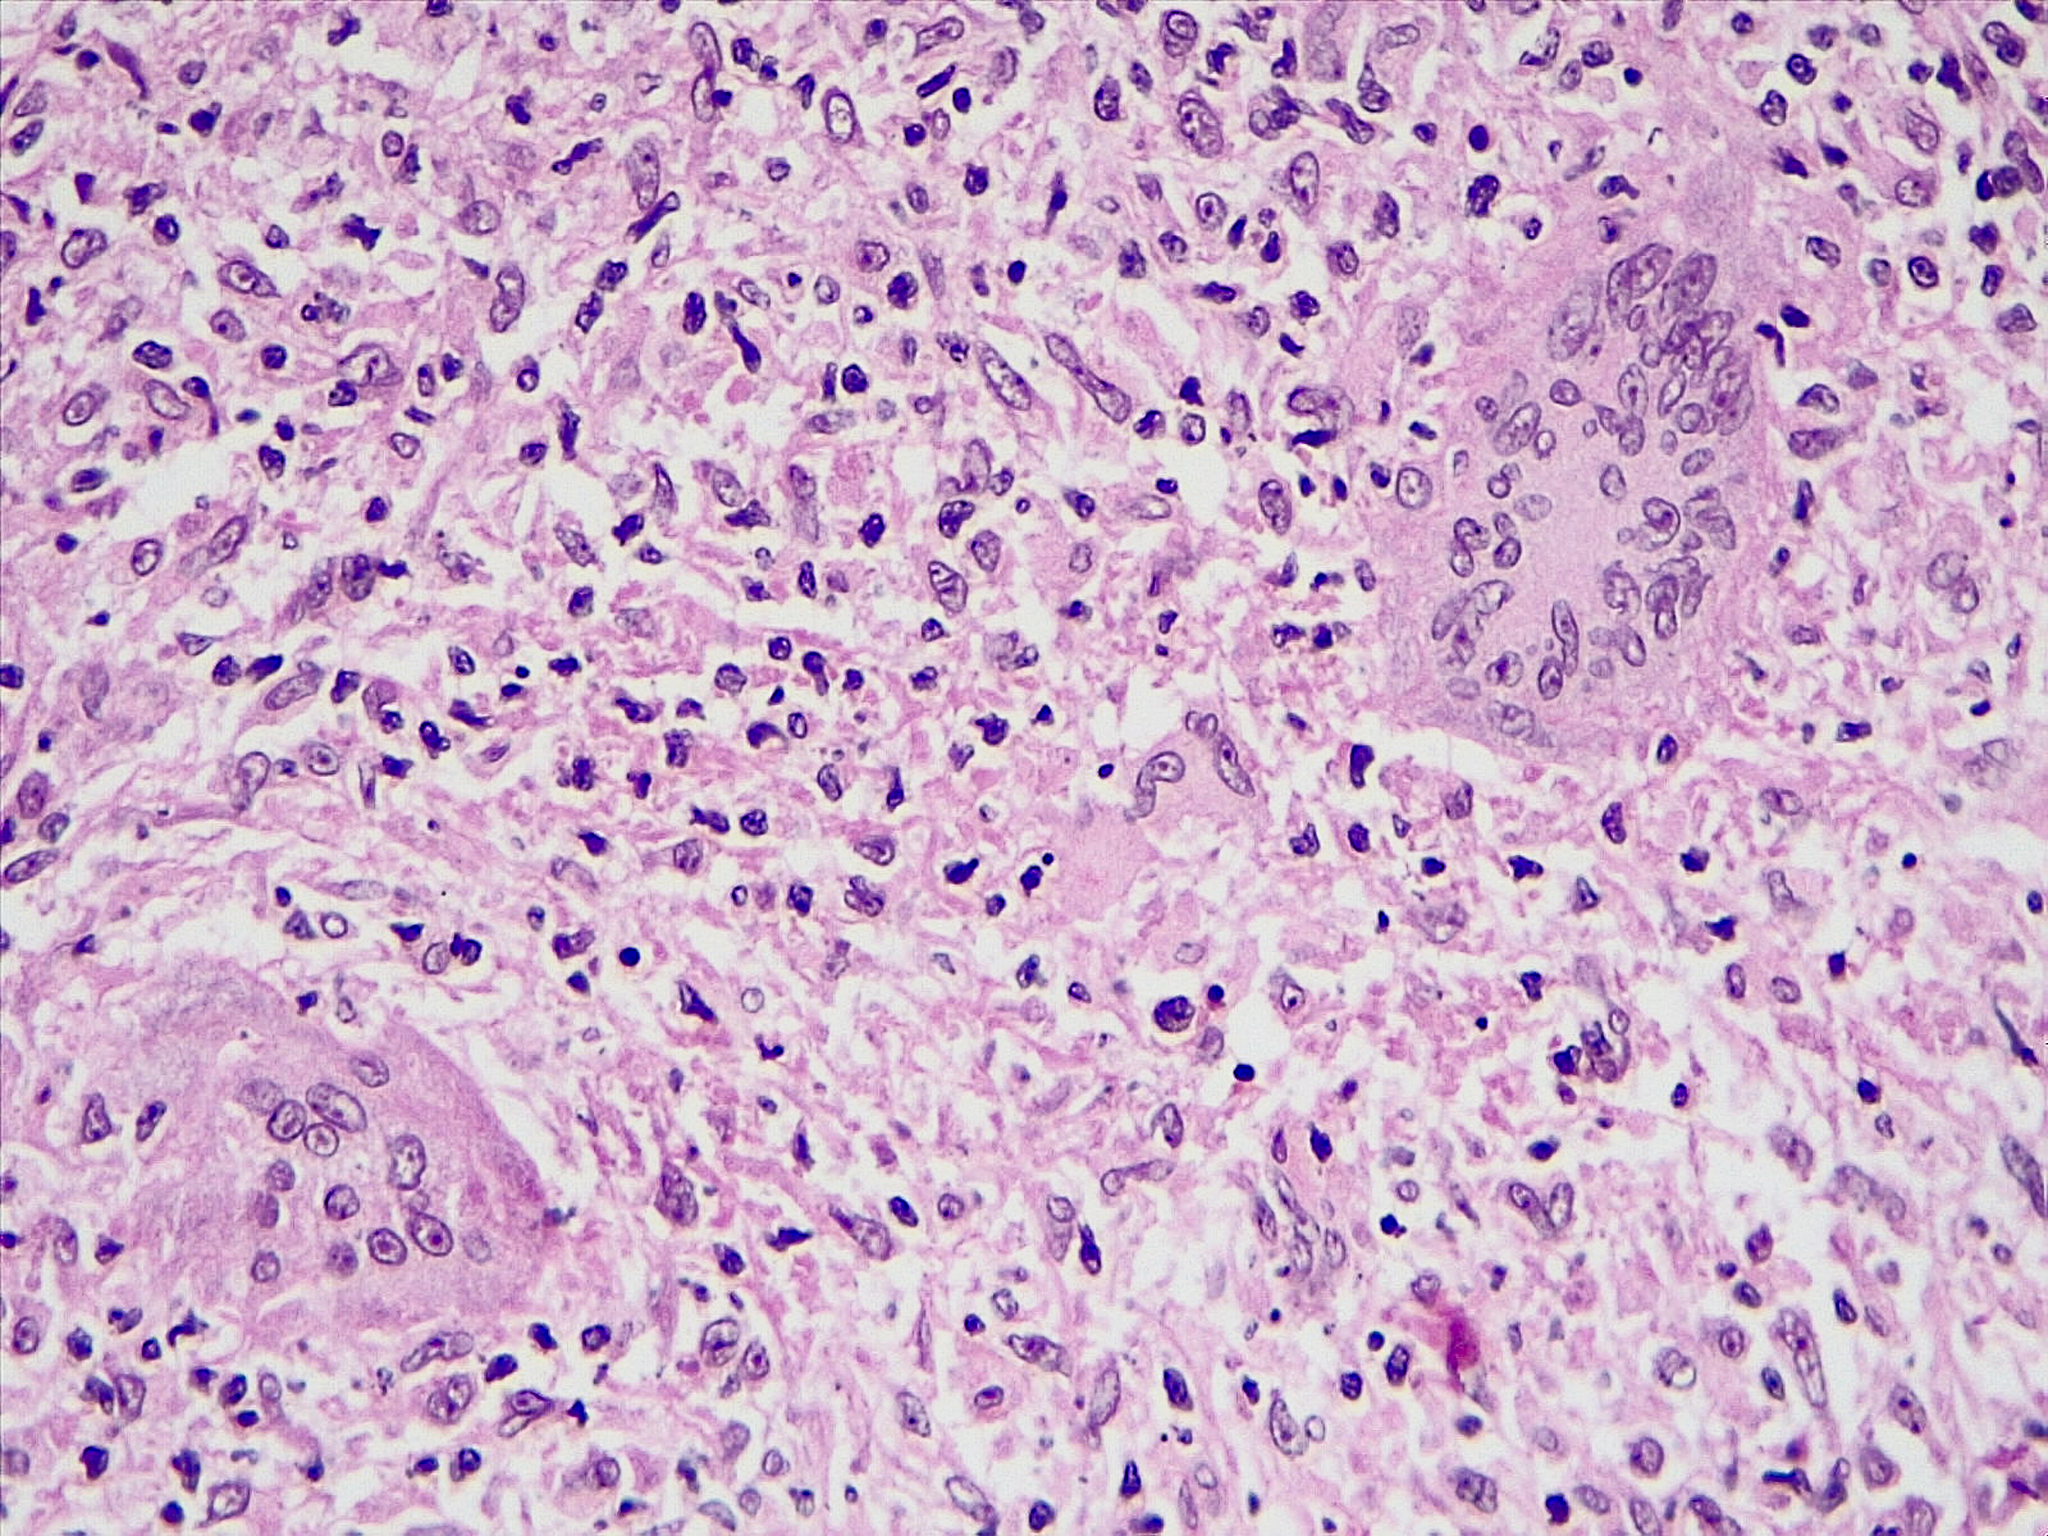
如何用光切显微镜测量表面粗糙度rz的值ra为何不宜测量

如何用光切显微镜测量表面粗糙度rz的值ra为何不宜测量
使用光切显微镜可以测量表面粗糙度rz的值。具体操作步骤如下:
-
准备光切显微镜,调节仪器,使其垂直于待测表面。
-
在表面上选择一个长度为5mm的测量区域,将测头放置在该区域上。
-
开始测量,仪器会自动扫描该区域,并获取相应数据。
-
在数据处理软件中,选择测量区域,计算出其rz值。
-
重复多次测量,取平均值作为最终结果。
相比之下,ra值不宜测量,因为它只能反映表面的平均粗糙度,而无法反映表面的峰谷高度差和表面形貌。在很多情况下,rz值更能反映表面的实际情况。
原文地址: https://www.cveoy.top/t/topic/b9Js 著作权归作者所有。请勿转载和采集!